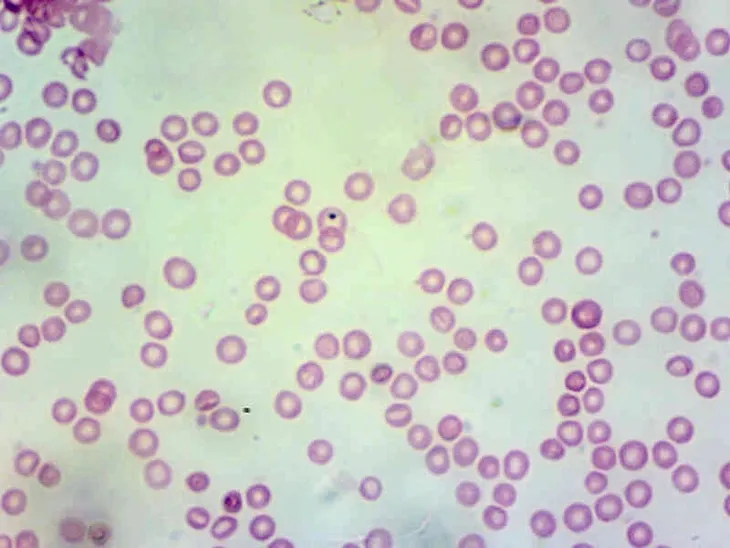
kamera-mikroskopowa-delta-optical-dlt-cam-basic-2-typ-mikroskopu-optyczny-model-dlt-cam-basic-2-mp-usb-2-0

Kamera mikroskopowa Delta Optical DLT-Cam Basic 2
Parametry
- Stan
- Nowy
- Faktura
- Faktura VAT
- Model
- DLT-Cam Basic 2 MP USB 2.0
- Kod producenta
- DO-4900
- Marka
- Delta Optical
- Typ mikroskopu
- optyczny
Opis produktu
Kamera mikroskopowa DLT-Cam Basic 2 MP USB 2.0
Kolorowa kamera mikroskopowa Delta Optical DLT-Cam Basic posiada sensor o rozdzielczości 2 megapikseli i działa na zasadzie cyfrowego okularu, który zastępuje standardowy okular w mikroskopie. W zestawie znajduje się oprogramowanie Delta Optical DLTCamViewer w pełni polskiej wersji językowej.
Zastosowanie cyfrowej kamery w połączeniu z mikroskopem i komputerem, poprzez interfejs USB 2.0, daje możliwość uzyskania podglądu obrazu mikroskopowego na żywo na ekranie komputera, a także pozwala na demonstrowanie preparatów mikroskopowych większej grupie słuchaczy w różnych, odległych miejscach sali – za pośrednictwem dużego ekranu, projektora multimedialnego lub tablicy interaktywnej. Dzięki kamerze Użytkownik może także w łatwy sposób zapisać zdjęcia i filmy z obrazu widzianego przez mikroskop, a także skorzystać z funkcji pomiarowych (po wcześniejszej kalibracji).
Montaż kamery polega na wsunięciu jej do tubusu okularowego mikroskopu, po wcześniejszym wyciągnięciu okularu. Kamera pasuje do tubusów okularowych o średnicy wewnętrznej 23,2 mm, które są spotykane w większości mikroskopów biologicznych (można także przeprowadzić montaż w tubusach nasadek trinokularowych). Natomiast w tubusach mikroskopów stereoskopowych (np. seria Delta Optical Discovery) kamerę można zamontować za pośrednictwem adapteru-tulejki 30,5 mm. Należy wiedzieć, że kamery z serii Basic, nie posiadające dedykowanego adaptera optycznego, dają znacznie mniejsze pole widzenia niż kamery z serii Pro. W zależności od mikroskopu, mogą pokazywać nawet ok. 30% pola widzenia widzianego w okularach.
Najważniejsze funkcje oprogramowania Delta Optical DLTCamViewer dołączonego do kamery:
- polska wersja językowa
- podgląd obrazu na żywo, z możliwością wyboru rozdzielczości
- zamrażane obrazu, skalowanie, dopasowanie do okna, podgląd pełnoekranowy, odbijanie obrazu w pionie i w poziomie w celu odpowiedniego odwzorowania
- tryb automatycznego poklatkowego zapisu obrazów (dostępne formaty: *.bmp, *.dib, *.rle, *.jpg, *.jpe, *.jpeg, *.jif, *.jfif, *.png, *.tif, *.tiff, *.pcx, *.tga, *.jp2, *.j2k, *.tft)
- wbudowana przeglądarka zapisanych obrazów (dostępne formaty: *.avi, *.wmv)
- regulacja czasu ekspozycji: automatyczna i manualna
- regulacja balansu bieli: automatyczna i manualna (temperatura barwowa)
- ręczne dopasowanie kolorów: odcień, nasycenie, jasność, kontrast, gamma
- praca w trybie kolorowym lub monochromatycznym oraz w trybie negatywu
- funkcja kalibracji długości względem wzorca i zapisywanie schematów kalibracji
- funkcje służące do przeprowadzania pomiarów geometrycznych: kąt, punkt, linia, linia równoległa, dwie linie równoległe, linie prostopadłe, prostokąt, elipsa, okrąg, okrąg wpisany w okrąg (pierścień), dwa okręgi, łuk, wielokąt - kalkulacja pola powierzchni oraz obwodów figur
- możliwość przeprowadzania pomiarów na zapisanych na zdjęciach oraz na obrazie na żywo
- możliwość wyeksportowania wyników pomiarów w formie tekstowej do arkusza kalkulacyjnego lub zapisania na obrazie
- dodawanie adnotacji tekstowych
- siatki i linijki, podziałka referencyjna pozwalająca odczytać aktualnie wykorzystywane powiększenie i skalę
- tworzenie i zarządzanie warstwami
- składanie stosu obrazów mikroskopowych zapisanych w osi Z w obraz o rozszerzonej głębi ostrości (funkcja EDF)
- funkcja "zszywanie" - łączenie obrazów mikroskopowych w panoramę 2D
- przetwarzanie obrazów przez różnorodne filtry oraz funkcję segmentacji
- funkcje automatycznego zliczania obiektów na obrazie
Automatyczna instalacja w systemach Windows Vista/2008/Windows 7/8/8.1/10 (32-bit oraz 64-bit). Kamera nie wymaga sterowników.
Pełna specyfikacja techniczna:
Nazwa modelu kamery: Delta Optical DLT-Cam Basic 2 MP:
- cyfrowa kolorowa kamera mikroskopowa
- maksymalna rozdzielczość: 1920x1080 pikseli (2 megapiksele)
- rozmiar sensora (przekątna): 1/2.8"
- wielkość piksela: 2.9 m x 2.9 m
- czułość: 1300 mV
- zakres dynamiki: 73 dB
- przetwornik analogowo-cyfrowy: 8-bit R.G.B
- odstęp sygnału od szumu: 43 dB
- liczba klatek na sekundę (FPS): 38 fps dla 1920x1080 pix; 38 fps dla 960x540 pix
- montaż w tubusach o średnicy wewnętrznej 23,2 mm
- interfejs: USB 2.0
- zasilanie: DC 5 V poprzez interfejs USB komputera
- dołączone polskojęzyczne oprogramowanie Delta Optical DLT-CamViewer z funkcjami podglądu obrazu na żywo, zapisu zdjęć oraz filmów, wbudowane funkcje -regulacji parametrów obrazu, filtry oraz funkcje pomiarowe
- w zestawie kabel USB do połączenia z komputerem, adaptery 30 mm i 30,5 mm

- Symbol u dostawcy: DO-4900
- Temperatura pracy: -10 / +50 C
- Sensor: CMOS
- Typ sensora: kolor
- Nazwa sensora: IMX307(C)
- Rozdzielczość sensora: 2 MP MP
- Rozdzielczość sensora (W x H): 1920 x 1080 pikseli
- Rozmiar piksela: 2,8 m
- Fizyczny rozmiar sensora: 5,73x4,30 mm
- Przekątna sensora: 1/2.8
- Zakres spektralny: 380 - 650 nm
- Interfejs danych: USB 2.0
- Obsługiwane rozdzielczości: 38 dla 960x540, 38 FPS dla 1920x1080
- Parametry zasilania: USB 5V
- Zakres czasów ekspozycji: 0,1 - 2000 ms
- Czułość: 1300 mV
- Wymagania systemowe: Windows (32 i 64 bit) Vista, 7, 8, 10
- Format zapisu video / zdjęć: *avi, *wmv, *mp4 / *jpg, *png, *tif, *jp2, *webp, *tft
- Wielkość piksela: 2.9 x 2.9 m
- Balans bieli: ROI/manualny
- Wyposażenie: adaptery 30 mm i 30,5 mm, kabel USB 2.0


adaptery 30 mm i 30,5 mm, kabel USB 2.0